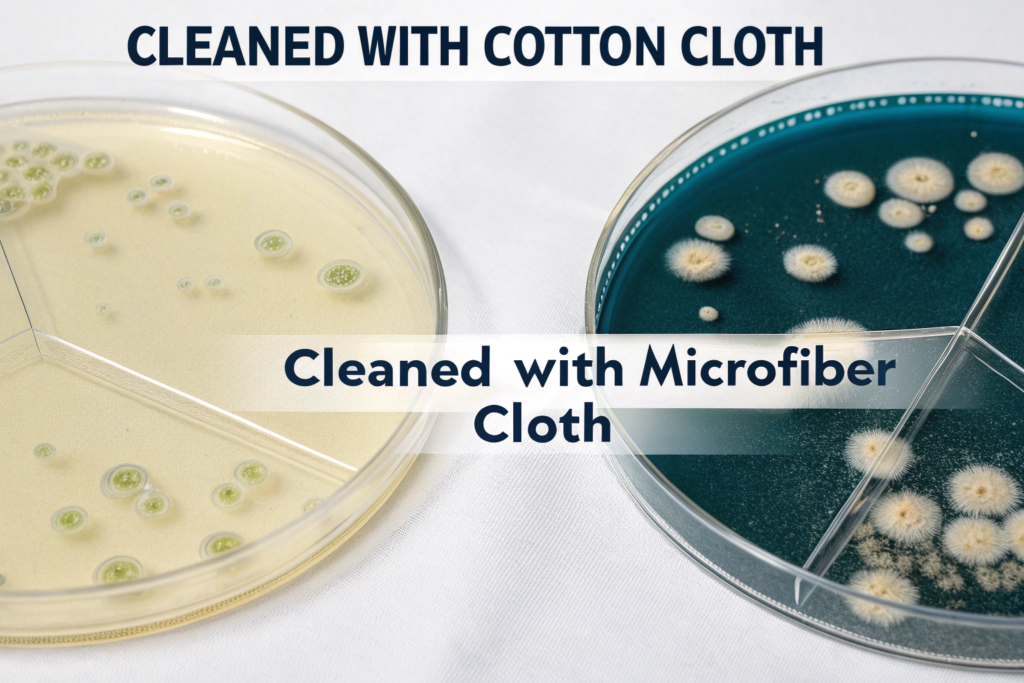

You're always looking for product categories that are driven by superior performance and tangible benefits. You've noticed the cleaning products aisle is dominated by one particular material: microfiber. From cloths for kitchen counters and car detailing to mops for hardwood floors, it's everywhere. You're asking a fundamental product development question: Is this just clever marketing, or is there a real, scientific reason why microfiber is so effective? Why should you, as a potential sourcer of home goods, invest in this material over a traditional cotton cloth?
Microfiber material is exceptionally good for cleaning cloths due to its unique physical structure at a microscopic level. Each fiber is engineered to be incredibly fine—100 times finer than a human hair—and is often split into a star-like cross-section. This structure creates a massive increase in surface area and a positive electrostatic charge, allowing the cloth to act like a magnet for dust, dirt, and microbes, trapping them within the fibers instead of just pushing them around. Furthermore, its high absorbency and streak-free performance make it vastly superior to traditional materials like cotton.
I'm the owner of Shanghai Fumao, and while our expertise is in fashion, the principles of material science are universal. We've worked with countless advanced textiles, and microfiber is a true marvel of modern engineering. It's not just a better cloth; it's a completely different technology. Understanding the science behind its effectiveness is the key to appreciating its value and communicating that value to your customers. Let's zoom in and explore why this material has revolutionized the cleaning industry.
How Does Microfiber's Structure Create a "Dirt Magnet"?
The magic of microfiber is not chemical; it's physical. It all comes down to the shape and size of the individual fibers. A traditional cotton cloth is, at a microscopic level, a collection of smooth, thick tubes. A microfiber cloth is a dense forest of incredibly fine, specially shaped strands.
The "dirt magnet" effect of microfiber is created by two key structural properties: its immense surface area and its electrostatic charge. The process of splitting the ultra-fine fibers into a star-shaped cross-section creates millions of sharp edges and tiny channels that physically scrape up and trap particles. Simultaneously, the friction of wiping generates a positive electrostatic charge that actively attracts and holds onto negatively charged dust particles, preventing them from being released back into the air.
Let's break down these two powerful mechanisms:
- Mechanical Cleaning (The "Scraping" Action):
- Ultra-Fine Fibers: Microfiber is defined as a fiber with a denier of less than 1.0. Denier is a measure of a fiber's fineness; for comparison, a human hair is about 20 denier and a strand of silk is about 8 denier. This extreme fineness allows microfiber to reach into microscopic pores and crevices on a surface that a thick cotton fiber would simply glide over.
- Split-Fiber Technology: During manufacturing, high-quality microfiber (typically a blend of polyester and polyamide) is "split." The process breaks the single fiber into numerous smaller, wedge-shaped strands, creating a star-like cross-section. This creates millions of tiny "blades" that are incredibly effective at scraping up and lifting dirt, grease, and even microscopic bacteria from a surface.
- Electrostatic Cleaning (The "Magnet" Action):
- Attracting Dust: When used dry, the friction of wiping a microfiber cloth across a surface generates a positive static charge. Since dust, lint, and most small particles have a slight negative charge, they are electrostatically attracted to the cloth and cling to it, much like a sock clings to a sweater in the dryer. This is why a dry microfiber cloth is so exceptionally good for dusting—it captures the dust instead of just kicking it up into the air.

What is the polyester/polyamide blend?
This is the classic recipe for a high-quality cleaning microfiber.
- Polyester: This component (typically 70-80% of the blend) is excellent for its strength and its ability to scrape and lift grease and dirt.
- Polyamide (Nylon): This component (typically 20-30%) is highly absorbent and helps to give the cloth its soft feel. It's the "sponge" part of the blend.
A cloth labeled "80/20" is 80% polyester and 20% polyamide. A higher percentage of polyamide generally indicates a higher quality, more absorbent cloth.
Does all microfiber have split fibers?
No, and this is a critical quality differentiator. The cheapest microfiber cloths, often sold in bulk at discount stores, are not split. They are simply made of very fine, unsplit fibers. While they are softer than cotton, they lack the "grippy" feel and the superior cleaning power of a true, split-fiber cloth. When sourcing, you must specifically ask your supplier if their microfiber is "split" or "splittable." A simple test is to run the cloth over the back of your hand; a split-fiber cloth will have a distinct "grippy" or "tacky" feel as it catches on the tiny imperfections in your skin.
Why is Microfiber So Absorbent and "Streak-Free"?
Beyond just picking up dust, a cleaning cloth needs to handle liquids—spills, cleaning solutions, and water for rinsing. Microfiber's performance with liquids is just as impressive as its performance with dry dust, and it's for a related reason: its massive surface area.
Microfiber is incredibly absorbent because its vast network of ultra-fine fibers creates an enormous surface area, allowing it to hold up to eight times its weight in liquid through capillary action. More importantly, it releases that liquid evenly and dries quickly, which is the key to its "streak-free" performance. Unlike a cotton cloth that dumps water in messy smears, a microfiber cloth applies and removes moisture in a controlled, microscopic layer, leaving behind a polished, residue-free surface.
Let's explore the science behind its liquid-handling abilities:
- Capillary Action: This is the same force that allows a tree to draw water up from its roots. The extremely small spaces between the millions of fine fibers in a microfiber cloth act like tiny straws. When the cloth touches a liquid, these spaces "pull" the liquid up into the cloth and hold it there. Because there are so many fibers, the total capacity for holding liquid is immense.
- The Streak-Free Finish: This is the holy grail of cleaning, especially on surfaces like glass, mirrors, and stainless steel. Streaks are caused by residue—either dirt or excess cleaning liquid—left behind on the surface.
- Microfiber excels here because it does two things at once: its sharp, split fibers scrape away and absorb any oily residue (like fingerprints), while its absorbent structure picks up almost all the moisture in a single pass.
- A cotton cloth, by contrast, gets saturated quickly and then just pushes the dirty water around, leaving a streaky film behind as it dries.
- Cleaning with Just Water: Because microfiber is so effective at mechanically lifting dirt and grease, it often eliminates the need for harsh chemical cleaners. For many everyday tasks, a microfiber cloth dampened with just water is enough to leave a surface perfectly clean. This is a major selling point for health-conscious and eco-conscious consumers. Major brands like E-Cloth have built their entire business model on this "just add water" concept.

What is GSM in the context of microfiber cloths?
Just like with scarves, GSM (Grams per Square Meter) is a critical quality indicator for microfiber. It measures the cloth's density and plushness.
- Low GSM (200-250): A thinner, lighter cloth, good for general-purpose, lightweight tasks like cleaning windows or glasses.
- Medium GSM (250-350): A good all-purpose weight. This is the workhorse of the category, suitable for most household cleaning tasks.
- High GSM (350+): A very thick, plush, and highly absorbent cloth. This is the premium choice, ideal for car detailing (drying and buffing) or for soaking up large spills.
A higher GSM generally means a more durable and more absorbent cloth, and it commands a higher price.
How do you wash and care for microfiber?
This is an important piece of consumer education. To maintain their effectiveness, microfiber cloths should be washed with other synthetic materials (not with cotton, which sheds lint that will clog the microfiber). They should be washed in cool or warm water, without fabric softener (which clogs the fibers and ruins the static charge), and can be tumble-dried on low heat. Proper care ensures the cloths last for hundreds of washings.
How Does Microfiber Contribute to a Healthier Home?
In today's health-conscious world, "clean" doesn't just mean visually clean; it also means hygienically clean. Consumers are more aware than ever of germs, bacteria, and allergens in their homes. This is another area where microfiber's physical structure gives it a significant, scientifically-backed advantage.
Microfiber contributes to a healthier home by physically removing up to 99% of bacteria and viruses from a surface using just water. The ultra-fine, split fibers are small enough to scrape up and trap these microscopic pathogens, holding them within the cloth until it is washed. This is a stark contrast to traditional cotton cloths, which tend to spread germs around and can become a breeding ground for bacteria themselves. This ability to achieve a high level of sanitation without relying on harsh chemical disinfectants is a major health benefit.
This hygienic cleaning capability is a key selling point:
- Physical Removal, Not Killing: It's important to be precise. Microfiber does not kill bacteria (it is not a disinfectant). It removes them from the surface. Studies by organizations like the EPA have shown that when used correctly, microfiber can be as effective as chemical cleaners at removing pathogens from surfaces in settings like hospitals and schools.
- Reducing Chemical Use: For many families, especially those with young children, pets, or individuals with allergies, reducing the use of harsh chemical disinfectants (like bleach or ammonia-based cleaners) is a high priority. Microfiber provides a powerful, effective way to achieve a high level of cleanliness with less reliance on these chemicals, leading to better indoor air quality and less chemical residue on surfaces.
- Allergen Removal: The same electrostatic properties that make microfiber great for dusting also make it fantastic for removing common allergens like pet dander, pollen, and dust mites. It traps these microscopic particles instead of sending them airborne, which can provide significant relief for allergy sufferers.
Positioning a microfiber cleaning product as a tool for creating a healthier, safer home environment is a powerful marketing angle that resonates deeply with modern consumers.
Can I claim my product is "antibacterial"?
You must be very careful with this language. A product that is "antibacterial" typically contains a chemical agent that kills bacteria (a biocide). A microfiber cloth does not do this. A more accurate and legally defensible claim would be: "Proven to remove 99% of bacteria from surfaces," or "Reduces the need for chemical disinfectants." Making false or unsubstantiated health claims can lead to serious legal trouble.
What about color-coding for hygiene?
This is a professional cleaning technique that has become popular in homes. The idea is to use different colored cloths for different areas to prevent cross-contamination. For example:
- Blue: for glass and general cleaning (low-risk areas)
- Green: for kitchen counters and food prep areas
- Yellow: for sinks and bathrooms (higher-risk areas)
- Red: for toilets (highest-risk areas)
Offering your microfiber cloths in a multi-color pack and explaining this system to your customers is a great way to add value and position your brand as an expert in cleaning.
Why is Microfiber a Durable and Eco-Friendly Choice?
In an era of growing environmental awareness, consumers are actively seeking products that are durable, reusable, and reduce waste. While microfiber is a synthetic, petroleum-based product, its incredible durability and reusability make it a surprisingly strong choice from an environmental and economic perspective when compared to the alternatives.
Microfiber is a durable and eco-friendly choice because a single, high-quality cloth can be washed and reused hundreds of times, drastically reducing the consumption of single-use paper towels and the need for disposable wipes. This long lifespan not only prevents a huge amount of waste from entering landfills but also offers a significant long-term cost saving for the consumer. Furthermore, its ability to clean effectively with just water reduces the amount of chemical cleaning solutions being washed down the drain and into the water system.
Let's analyze the durability and environmental benefits:
- Extreme Durability: A well-made, split-fiber microfiber cloth is designed for professional use and can withstand 300 to 500 (or even more) launderings before it starts to lose its effectiveness. This incredible durability is a core part of its value proposition.
- Waste Reduction: The average US household uses dozens of rolls of paper towels every year. By replacing the majority of paper towel usage with a small set of reusable microfiber cloths, a family can prevent a massive amount of paper waste. This is a powerful and easily understood environmental benefit.
- Long-Term Cost Savings: While a single microfiber cloth costs more than a single paper towel, the long-term economics are overwhelmingly in microfiber's favor. A small investment in a set of quality cloths can save a consumer hundreds of dollars over a few years compared to the endless purchasing of disposable paper products. This is a compelling argument for any budget-conscious shopper.
- Reduced Chemical Pollution: Every time someone uses a harsh chemical cleaner, those chemicals eventually end up in the water supply. By enabling effective cleaning with just water, microfiber helps to reduce this chemical burden on the environment.

What about the issue of microplastic pollution?
This is a valid and important concern. When synthetic fabrics like microfiber are washed, they can shed tiny plastic fibers that can enter the waterways. This is a complex environmental issue for all synthetic textiles. As a brand, you can address this proactively by:
- Recommending that customers wash the cloths in a special laundry bag (like a Guppyfriend bag) that is designed to capture these microfibers.
- Highlighting that the overall waste reduction from eliminating paper towels is a significant net positive for the environment.
- Sourcing cloths made from recycled materials (like rPET), which at least addresses the "front-end" of the plastic lifecycle.
Acknowledging this issue and offering solutions shows that you are a transparent and responsible brand.
How can I test the durability of a supplier's cloth?
When you get samples from a potential supplier, you can perform a simple but effective "torture test." Take one cloth and wash it 20-30 times with a load of towels (following the proper care instructions). Does it still feel effective? Is it falling apart? A high-quality cloth will look and feel almost new, while a low-quality one will quickly lose its plushness and start to fray.
Conclusion
Microfiber's dominance in the cleaning industry is not a marketing fad; it is a clear victory of superior science and engineering. Its unique, split-fiber structure creates a "dirt magnet" that mechanically and electrostatically removes dust, dirt, and even bacteria from surfaces. Its incredible absorbency and quick-drying properties deliver a streak-free clean that traditional materials cannot match. This ability to achieve a higher level of clean with less effort and fewer chemicals makes it a powerful tool for creating a healthier home. Finally, its exceptional durability and reusability offer a compelling environmental and economic argument against disposable alternatives. For a brand owner, microfiber is a product category rich with demonstrable benefits and powerful value propositions.
While we at Shanghai Fumao specialize in fashion, we have a deep appreciation for the power of advanced materials. The same principles of sourcing high-quality, technically proficient textiles apply whether you are making a performance headband or a high-performance cleaning cloth. Understanding the science behind your product is the first step to creating a brand that is built on a foundation of genuine quality and trust. If you are exploring sourcing any kind of textile-based product, partnering with a manufacturer who understands material science is key. To learn more about our approach to quality manufacturing, please reach out to our Business Director, Elaine, at elaine@fumaoclothing.com.










